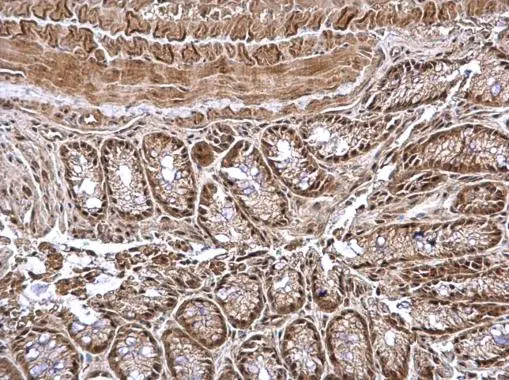
CSN1 antibody detects CSN1 protein at nucleus on mouse colon by immunohistochemical analysis. Sample: Paraffin-embedded mouse colon. CSN1 antibody (GTX114450) dilution: 1:500. Antigen Retrieval: Trilogy? (EDTA based, pH 8.0) buffer, 15min

CSN1 antibody detects CSN1 protein at nucleus on mouse liver by immunohistochemical analysis. Sample: Paraffin-embedded mouse liver. CSN1 antibody (GTX114450) dilution: 1:500. Antigen Retrieval: Trilogy? (EDTA based, pH 8.0) buffer, 15min
CSN1 antibody
GTX114450
ApplicationsImmunoHistoChemistry, ImmunoHistoChemistry Paraffin
Product group Antibodies
ReactivityHuman, Mouse
TargetGPS1
Overview
- SupplierGeneTex
- Product NameCSN1 antibody
- Delivery Days Customer9
- Application Supplier NoteIHC-P: 1:100-1:1000. *Optimal dilutions/concentrations should be determined by the researcher.Not tested in other applications.
- ApplicationsImmunoHistoChemistry, ImmunoHistoChemistry Paraffin
- CertificationResearch Use Only
- ClonalityPolyclonal
- Concentration1 mg/ml
- ConjugateUnconjugated
- Gene ID2873
- Target nameGPS1
- Target descriptionG protein pathway suppressor 1
- Target synonymsCOPS1, CSN1, SGN1, COP9 signalosome complex subunit 1, JAB1-containing signalosome subunit 1
- HostRabbit
- IsotypeIgG
- Protein IDQ13098
- Protein NameCOP9 signalosome complex subunit 1
- Scientific DescriptionThis gene is known to suppress G-protein and mitogen-activated signal transduction in mammalian cells. The encoded protein shares significant similarity with Arabidopsis FUS6, which is a regulator of light-mediated signal transduction in plant cells. [provided by RefSeq, Mar 2016]
- ReactivityHuman, Mouse
- Storage Instruction-20°C or -80°C,2°C to 8°C
- UNSPSC12352203